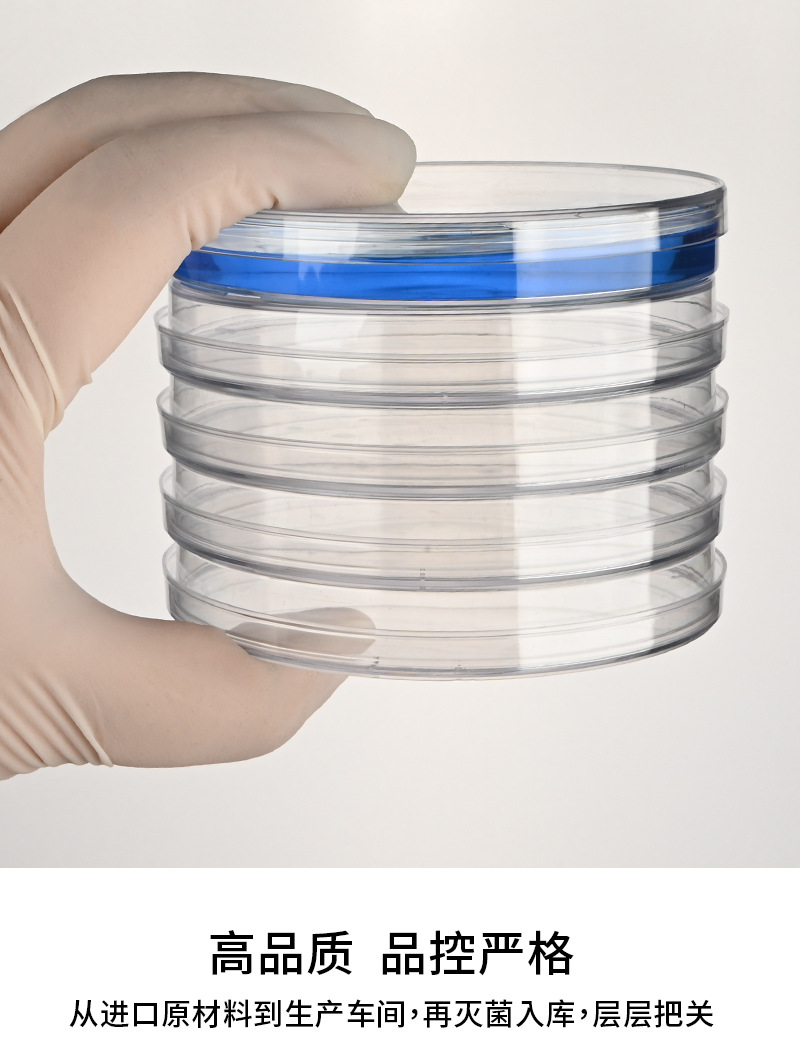
undefined

Устранимая пластиковая чашка Петри клетки чашки Петри 55 мм 60 мм 70 мм 90 мм 100 мм 150 мм













Продано за 30 дней:
19036 шт.
Всего продаж:
8500295 шт.
Минимальное количество для заказа:
1 шт.
Устранимая пластиковая чашка Петри клетки чашки Петри 55 мм 60 мм 70 мм 90 мм 100 мм 150 мм
от 2.43 ₽ за 1 шт.
-21%
2.43 ₽
Доставка по Китаю включена в цену
Оптом
от 1 шт.
1.88 ₽
от 1 шт.
2.43 ₽
Описание
一次性塑料培养皿 植物培养皿 一次性耗材 培养皿
35mm培养皿2000套一箱
55mm培养皿1000套一箱
60mm培养皿1000套一箱
70mm培养皿1000套一箱
90mm培养皿500套一箱
100mm培养皿500套一箱
10*10mm培养皿500套一箱
13*13mm培养皿300套一箱
150mm培养皿180套一箱

Характеристики
Происхождение:
Цзянсу, Китай
Страна/регион происхождения:
Китай
Пункт Нет.:
01-07-2020
Марка:
Дабо
Технические характеристики:
35 мм; 60 мм; 90 мм; 100 мм; 150 мм; 55 мм; 70 мм; Толщина 90 мм; 90 мм очень толстый; Высота 90 мм; Двухсторонняя решетка 90 мм; 90 мм тройной; 100*100 мм квадратное блюдо; 130*130 квадратное блюдо; 35 мм целая коробка; 55 мм целая коробка; Вся коробка 60 мм.; 70 мм целая коробка; 90 мм обычная целая коробка; Целая коробка толщиной 90 мм; 90 мм очень толстая полная коробка; Полная коробка с двумя отсеками 90 мм; Полная коробка с тремя отсеками 90 мм; 90 мм Повысьте всю коробку; 100 мм ФКЛ; 100*100 квадратных блюдо целая коробка; 130*130 квадратная пластина FCL; 150 мм Полная коробка
Модель:
35 мм-150 мм
Цена единицы продукта:
0,15
О продавце
Имя:
Оценка предложения:
5.0
Оценка сервиса:
4.5
Оценка споров и жалоб:
5.0
repeatPurchasePercent:
0.5589863372876959
Оценка логистики:
4.5
qualityRefundWithin30Day:
0.0
afterSalesExperienceScore:
5.0
Оценка консультации:
4.0
collect30DayWithin48HPercent:
1.0

Устранимая пластиковая чашка Петри клетки чашки Петри 55 мм 60 мм 70 мм 90 мм 100 мм 150 мм
2.03 ₽
2.03 ₽








